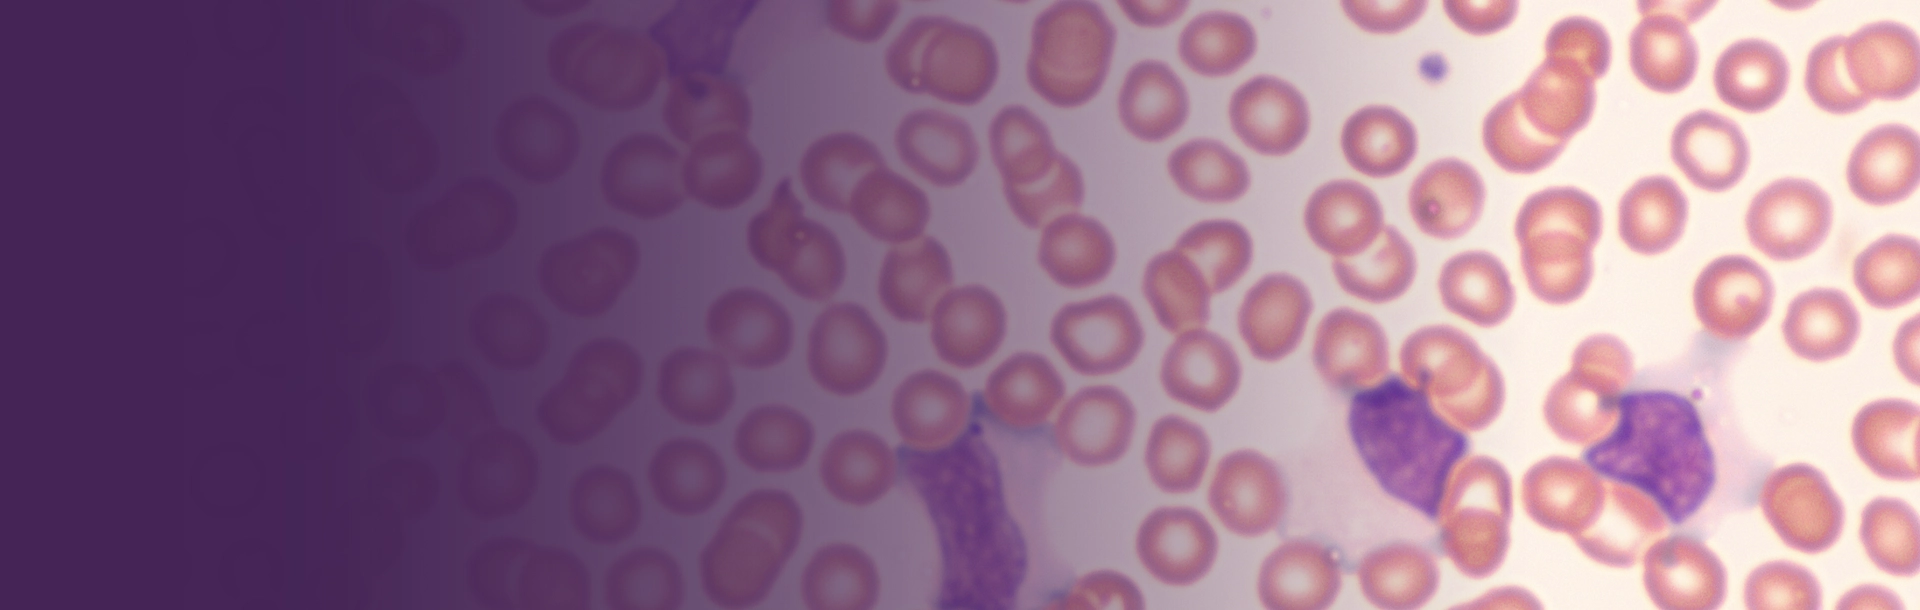

La mononucleosis infecciosa, conocida popularmente como la enfermedad del beso porque se transmite principalmente por contacto directo con la saliva de una persona infectada, es un trastorno infeccioso agudo que se manifiesta, sobre todo, con fiebre, inflamación de los ganglios cervicales y faringitis con dolor de garganta. Coincidiendo con el Día Internacional del Beso, que se celebra el 13 de...
This article is for subscribers only
Login to your account to continue reading.
This publication is restricted to registered pharmacists, and its dissemination among the general public or other health professionals is not intended.